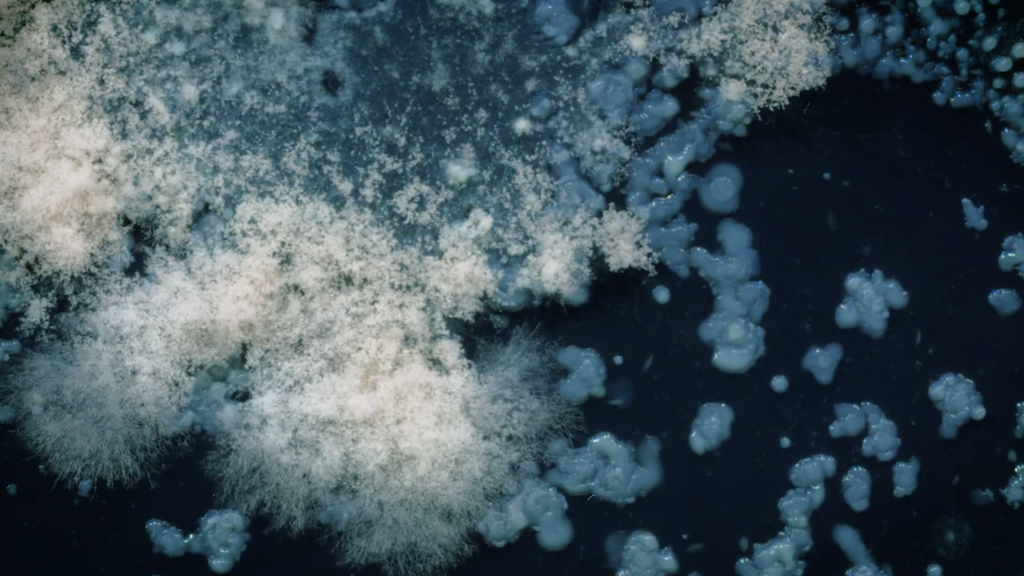

Artist Jamie House presents a unique ambisonic listening event at CAST as part of his ongoing collaboration with Natural England at Goonhilly Downs SSSI. The audience is invited to experience a 10-speaker soundscape revealing the hidden sonic worlds of this extraordinary Cornish landscape.
Doors open at 5.15pm. An introductory talk will precede a 45-minute listening experience in the black box from 5.45 – 6.30pm, followed by a Q&A.
An independent production by Jamie House, presented in the black box at CAST.